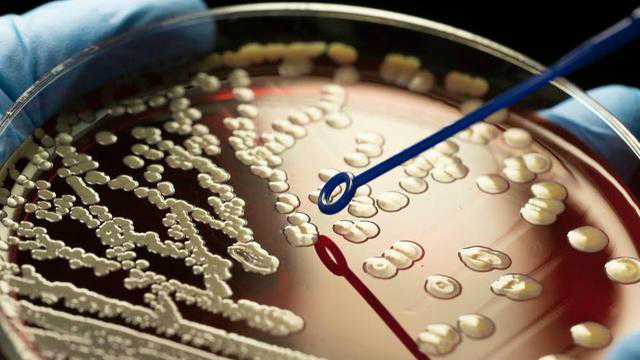

细菌的繁殖速度非常快,比如酵母,它们繁殖一代只需要12分钟。 当一个菌群所在的环境发生变化时,不具备适应能力的细菌个体会迅速被大量淘汰,剩下的适应性个体会在短时间内大量繁殖,最终整个 植物群将具有适应性。当青霉素在 1940 年代首次发明时,它被称为神药,几乎可以治愈细菌感染。 然而几年后,葡萄球菌率先适应并对青霉素产生抗药性。 现在青霉素对许多细菌不起作用,尽管人类不断研发新的抗生素(如红霉素、链霉素),但抗生素的研发速度最终会跟不上细菌变异的速度。
抗生素耐药性现在已成为一颗定时炸弹。 世界卫生组织预测,到 2050 年,死于感染的人数将超过死于癌症的人数,因为到那时,许多细菌已经对抗生素产生了足够的抗药性来对抗它们。 原因是细菌善于适应,当生存受到威胁时,它们会发生变异,从而不再受到抗生素的威胁。
研究人员的实验表明,脂肪酸具有抗菌作用,即可以杀死李斯特菌。 起初,这听起来不错,但随后出现了突变,试图杀死细菌只会将其突变为新的耐药形式。 这个结局看起来像抗生素……

但这些脂肪酸有一个特殊的天赋:它们可以使耐药细菌失去能力,因此根本不会发生感染。 因此通过剥夺它杀死细菌的能力,细菌不会变异而产生抗药性,但仍然可以防止它们传播和感染。

使致病细菌无法传播或使我们生病的概念被称为毒力关闭。 当你关闭一种细菌的毒力时,你就可以阻止它产生像粘附素和侵袭素这样的蛋白质,细菌需要附着在细胞上才能进入细胞。 “如果李斯特菌不能进入细胞,它就不能传播,也不会发生感染,”Callipolitis 教授解释说。